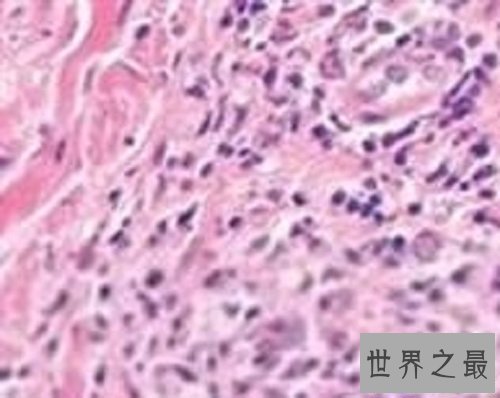
【图】女性男性的最大克星除了癌症还有淋病淋病的症

女性不断是应该被捧在手上的珍珠,然而宽广的女性应该要知道咱们不只有被他人保护,本人也要爱惜本人。从古至今多少美女消香玉损在如花的年岁,那这到底是为什么会有这种现象呢?原来罪魁祸首竟是淋病,淋病有哪些症状?咱们要如何防备于已然?今天小编就给女性们男性普及一些淋病的症状,爱他她的同时,更要爱本人。
1、淋病初期症状
淋病的早期症状: 一:尿道出现分泌物:若尿道口出现脓性分泌物,稀薄量多色黄,晨起尤甚,则能够为急性淋病;若尿道口有透明的粘性分泌物,量少,则能够为非淋菌性尿道炎。 二:尿道会有瘙痒感:男性出现此淋病早期症状症状,多思考为非淋菌性尿道炎或淋菌性尿道炎的早期反应。

三:男性出现尿频、尿急、尿痛、尿道口红肿:男性出现此症状,若伴有夜间阴茎痛性勃起者,多思考为急性淋病性尿道炎。 四:外阴部赘生物:若在外阴或肛周处,见多发性浸润性、灰白色、扁平隆起性丘疹或结节,且湿润易腐败,伴有臭味,多思考为扁平湿疣(梅毒螺旋体感染);若在外阴或肛周处,见淡红色或灰褐色,菜花状或鸡冠状且有蒂的疣状物,易出血,多思考为锋利湿疣;若在肛周或外阴部,见米粒大的半球形丘疹,地方有脐窝,外表有蜡样光泽,顶端挑破可挤出乳酪样物质,招思考为传染性软疣。

五:外阴部溃疡:若为圆形溃疡,软骨样硬,不痛,单发,多思考为硬下疳(梅毒);若溃疡柔软,边缘如锯齿状,较浅,伴有疼痛,多发伴有脓苔,多思考为软下疳;溃疡若由簇集水疱演化而成,质软且疼痛,多思考为生殖器疱疹。 成都九龙医院男科专家提示得了淋病越早治疗越好: 依据性流传疾病大量临床治疗阅历总结,专家得出论断:性流传疾病的最佳治疗工夫是染病后的1-2天以内,而且是越早治越好,由于此时治疗可很容易肃清细菌和病毒,防止病情的发展和扩展,一旦迁延不治,则添加临床治疗的难度。 顺便要指出的是,一旦发生了不洁性行为,即使采用了平安措施,仍要留意本人的身材变化。假设出现了淋病的典型症状,如尿频尿急尿痛、尿道口流脓等,肯定要及时去医院治疗。除艾滋病外,各大性病都是早期容易治疗,拖得越久,治疗就越费事。
2淋病晚期症状
怎样判别淋病能否进入晚期了呢,咱们持续随武汉性医院专家来了解一下淋病的晚期症状体现。 ? 1、患者出现腰痛、会阴坠胀,夜间遗精频繁以及血精的症状。 2、排尿时出现尿痛的感觉,或许尿道灼热以及刺痛的感觉,甚至还会出现血尿的现象。

3、男性淋病常可并发尿道炎、尿道周围组织炎和脓肿、输精管炎、精囊炎、附睾炎、睾丸炎、鞘膜积液、前列腺炎、包皮龟头炎、淋菌性溃疡等。

4、排尿艰巨、尿线细弱、射程短,甚至尿潴留。附睾炎多见于治疗不迭时者,常突然感到附睾疼痛、肿大、压痛、发热。 淋病晚期治疗大意不得,抉择一家规范的医院是基本。武汉机关总医院性病科是武汉三甲公立的大型医院,同时也是武汉市医保定点医院,医院对于性疾病的治疗有着资深的专家主任和一系列的独到疗法。对于淋病的治疗,武汉机关总医院性病科采用了;生物渗透染指疗法疗程短,见效快,治疗淋病防复发,对于早晚期的淋病均有着确切的疗效。 ;生物渗透染指疗法;为何遭到医学界同仁分歧推崇,通过专家的钻研和临床实际,得出以下几点 强效杀菌:生物渗透染指疗法应用微米红光骶神经节染指以其独有的激活因子,超强的渗透作用,使药物直达病灶,快速准确地辨认病毒或病菌,使药物达到了极佳的治疗浓度,其对潜伏在体内血液、皮肤基底层、生发层细胞和神经节内的病毒或病菌停止齐全杀灭。 片面排毒:采用染领导光波停止免疫抗病毒治疗,经过干扰淋病病毒的DNA合成,让病毒在分子生物基因层就受到阻击,其治疗机头垂直射几十秒至一分钟,齐全杀灭淋病病毒,新陈代谢排出病毒及DNA残片,防止残片重组。 系统修复生物渗透染指疗法;促进让武汉机关总医院性病科的特效药物中富裕的;粘膜修复因子;快速修复病变的组织和受损细胞,消弭代谢阻碍,纠正免疫毛病,有效恢复机体性能。 激活免疫:将发病形态病毒和亚临床形态的病毒控制、肃清后,刺激机体产生保护性免疫来防止病毒再感染,有效杜绝淋病病毒复发。
3预防
